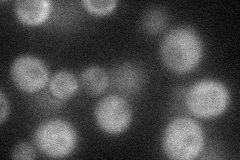
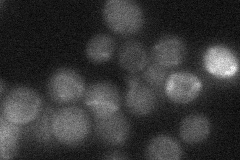
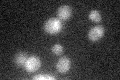

View description
Regulatory subunit for Glc7p type-1 protein phosphatase (PP1), tethers Glc7p to Gsy2p glycogen synthase, binds Hsf1p heat shock transcription factor, required for induction of some HSF-regulated genes under heat shock
Localization:
Intensity:
Fold change:
Significance:
-
C’ GFP library in SD

below threshold16.55 -
N' NOP1pr-GFP in SD
cytosol37.634 -
N' TEF2pr-mCherry in SD

below threshold6.22877 -
N' NATIVEpr-GFP in SD
below threshold21.1098 -
N' TEF2pr-VC and Cyto-VN in SD

#N/A0 -
C’ GFP library in SD+DTT

ambiguousN/AN/ANo -
C’ GFP library in SD+H2O2

ambiguousN/AN/ANo -
C’ GFP library in Starvation Media
ambiguousN/AN/AYes -
C’ GFP library on the background of Pup2-DaMP

below threshold -
C’ GFP library on the background of CCT mutant

below thresholdN/AN/ANo
